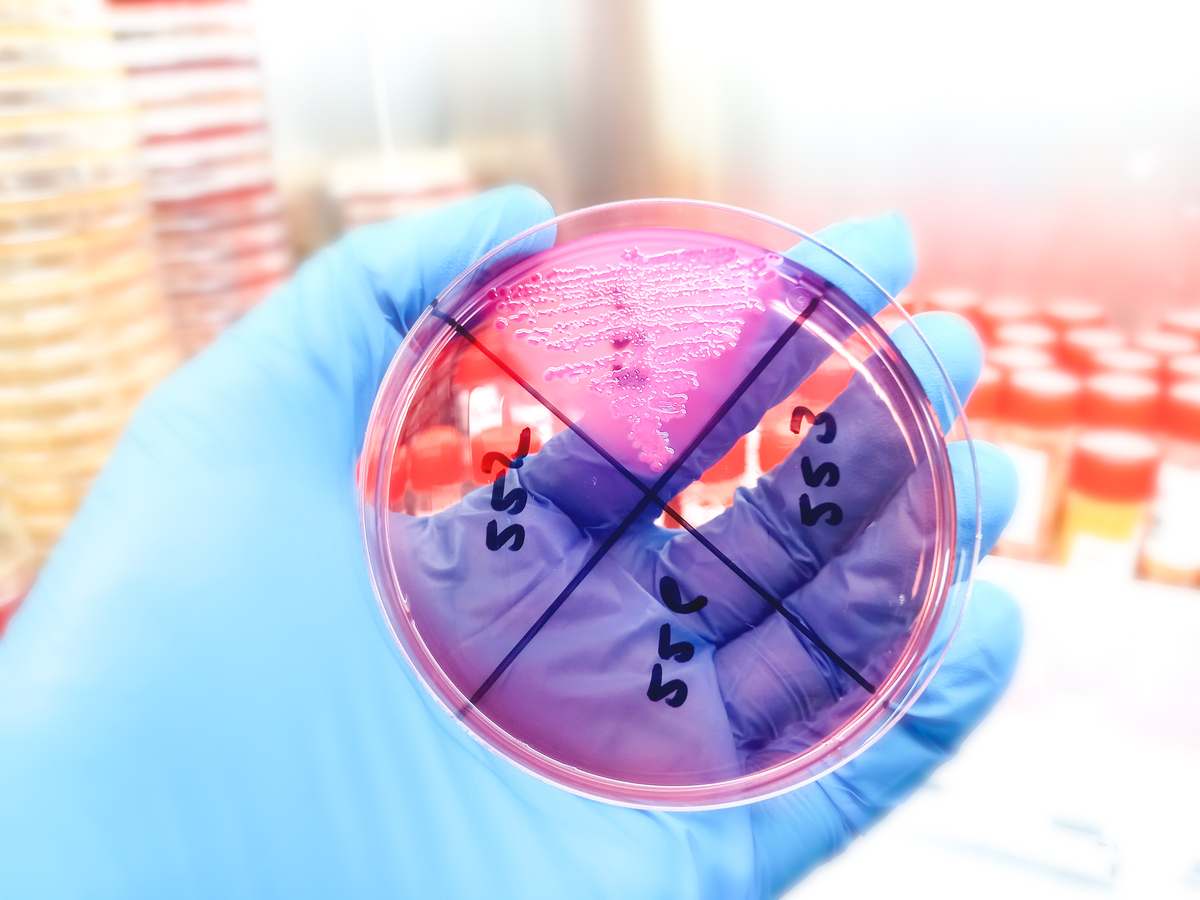
FOOD MICROBIOLOGY期刊的介绍？

FOOD MICROBIOLOGY期刊的介绍?
FOOD MICROBIOLOGY是一本国际性的学术期刊,专注于食品微生物学领域的研究。该期刊旨在促进对食品微生物和食品安全的理解,并为研究人员和从业人员提供一个交流和分享他们的研究成果的平台。
FOOD MICROBIOLOGY的论文涵盖了广泛的主题,包括食品中的微生物生长、食品中的微生物污染、食品加工和保存中的微生物控制、食品中的病原微生物、食品中的益生菌和功能性微生物、食品中的抗生素抗性、食品中的微生物毒素等。
该期刊的目标读者包括食品微生物学研究人员、食品科学家、食品安全专家、食品工程师以及相关领域的从业人员。期刊发表的论文经过同行评审,确保其质量和学术价值。
FOOD MICROBIOLOGY是一个重要的学术资源,为食品微生物学领域的研究和发展做出了重要贡献。研究人员和从业人员可以通过阅读该期刊的论文,了解最新的研究进展、技术和方法,以及食品微生物学领域的最新趋势和挑战。
原文地址: https://www.cveoy.top/t/topic/jfXI 著作权归作者所有。请勿转载和采集!